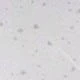
trắng

Menodora SHEIN Sport Quần lót thể thao nữ cạp chun nhún bèo hàng ngày
SKU: st25062369666960119
Price and availability
63.000₫
Màu sắc:trắng
Ảnh lớn

Kích thước
S
M
L
Hướng dẫn kích thước
Tìm hiểu thêm
An ninh mua sắm
Thanh toán an toàn
Bảo vệ quyền riêng tư
